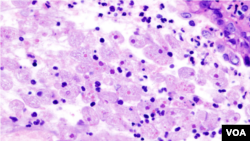
نگلیریا کے جراثیم

کراچی میں گندگی اور نکاسی آب کے نظام کی بدترین صورت حال کے باعث مختلف بیماریاں پھیل رہی ہیں جن میں چکن گنیا،ڈینگی ،ملیریا ،ڈائریا وغیرہ شامل ہیں۔
لیکن اب شہریوں کو پانی استعمال کرتے ہوئے مزید احتياط سے کام لینا ہو گا۔ شہر میں نگلیریا بیماری نے پھر سر اٹھا لیا ہے۔ حالیہ چند دنوں میں دوافراد نگلیریا کا شکار ہوکر جان سے ہاتھ دھو بیٹھے ہیں۔
مزید تشویشناک صورت حال یہ ہے کہ شہریوں کو کلورین ملائے بغیر پانی فراہم کیے جانے کا انكشاف ہوا ہے۔ محکمہ صحت کی انسداد نگلیریا کمیٹی نے شہر کے 246 علاقوں سے پانی کے نمونے حاصل کیے۔ جب پانی کے تجزیے کیے گئے تو انكشاف ہوا ہے کہ 157 علاقوں میں شہریوں کو ملنے والے پانی میں کلورین کی مخصوص مقدار شامل ہی نہیں۔
یہ نمونے کراچی کے گنجان آباد علاقوں گلشن اقبال، نیوکراچی، ناظم آباد، فیڈرل بی ایریا، حسین آباد، سرجانی، کورنگی اور دیگر علاقوں سے حاصل کیے گئے۔ گرمی سے بے حال شہری سوئمنگ پولز میں نہانے سے پہلے سوچ لیں کہ کہیں تفریح قیمتی جان سے محروم ہی نہ کر دے۔
انسداد نگلیریا کمیٹی نے شہر کے سوئمنگ پولز سے بھی پانی کے نمونے حاصل ۔ 37 سوئمنگ پولز میں سے صرف 2 میں کلورین موجود تھی۔
انسداد نگلیریا کمیٹی کےترجمان ڈاکٹر ظفر مہدی کے مطابق گرمیوں کے مہینوں میں نگلیریا زیادہ پھیلتا ہے۔ اس موسم میں جرثومہ کی افزائش ہوتی ہے۔ 50فیصد سے زیادہ شہریوں کو بغیر کلورین ملا پانی فراہم کیا جا رہا ہے۔ اس کی روک تھام کا واحد طریقہ پانی میں کلورین کی آمیزش ہے۔ اور کلورین کی مقدار پانی میں شامل کرنے کی ذمہ داری واٹر بورڈ کی ہے۔
وائس آف امریکہ کے نمائندے نے واٹر بورڈ سے اس حوالے سے بات کی تو ان کے ترجمان کا کہنا تھا کہ واٹر بورڈ پانی میں کلورین کی مخصوص مقدار کو شامل کرتا ہے۔ تاہم ہو سکتا ہے زیادہ گرمی پڑنے، پرانی اور خستہ پائپ لائنوں کی وجہ سے کلورین کا اثر گھروں تک پہنچتے پہنچتے ختم ہو جاتاہو۔
ماہرین کا کہناہے کہ نگلیریا صرف پینے کے پانی کے ذریعے ہی جسم میں داخل نہیں ہوتا بلکہ گھروں میں نہانے یا سوئمنگ پول ،جھیل ،تالاب یا دریا میں نہاتے ہوئے بھی ناک کے ذریعے جسم میں داخل ہو سکتا ہے اور جسم میں داخل ہوتے ہی یہ دماغ کا رخ کرتا ہے اور دماغ کو کھا کر انسان کو ہلاک کر دیتا ہے۔
ماہرین کا شہریوں کو مشورہ ہے کہ وہ گھر میں پانی کے ٹینکوں کو ہفتے میں دو مرتبہ صاف کریں اور کلورین کی گولیاں کا استعمال کریں۔